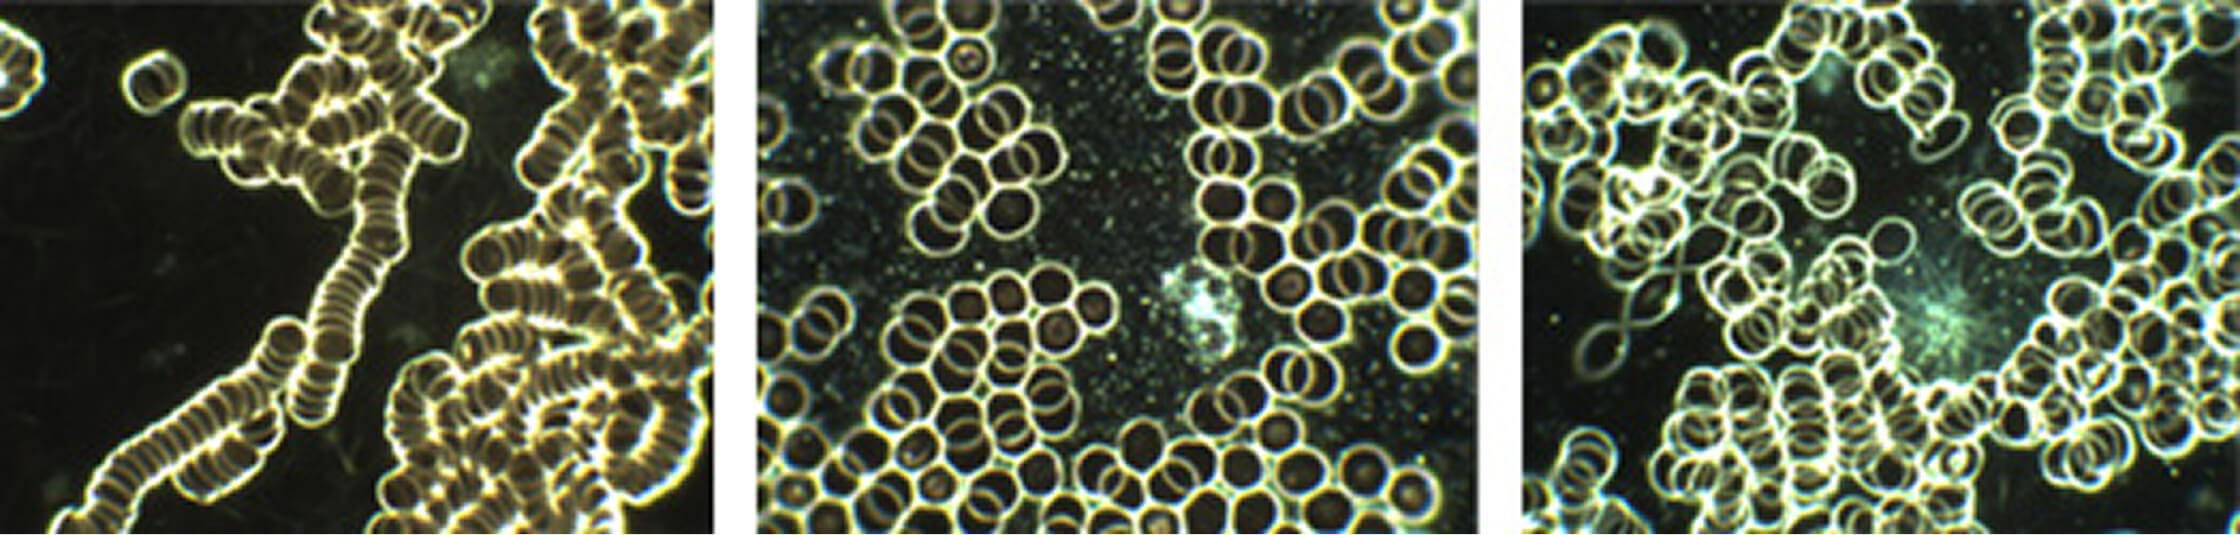

Dunkelfeld
mikroskopie
(Vitalblut-Untersuchung)
Es wird ein kleiner Tropfen Blut aus dem Ohr oder Finger entnommen und direkt auf einen Objektträger gegeben. Ohne Färbung oder Fixierung wird das Vitalblut im speziellen Dunkelfeld
Dunkelfeldmikroskopie
(Vitalblut-Untersuchung)
Es wird ein kleiner Tropfen Blut aus dem Ohr oder Finger entnommen und direkt auf einen Objektträger gegeben. Ohne Färbung oder Fixierung wird das Vitalblut im speziellen Dunkelfeld